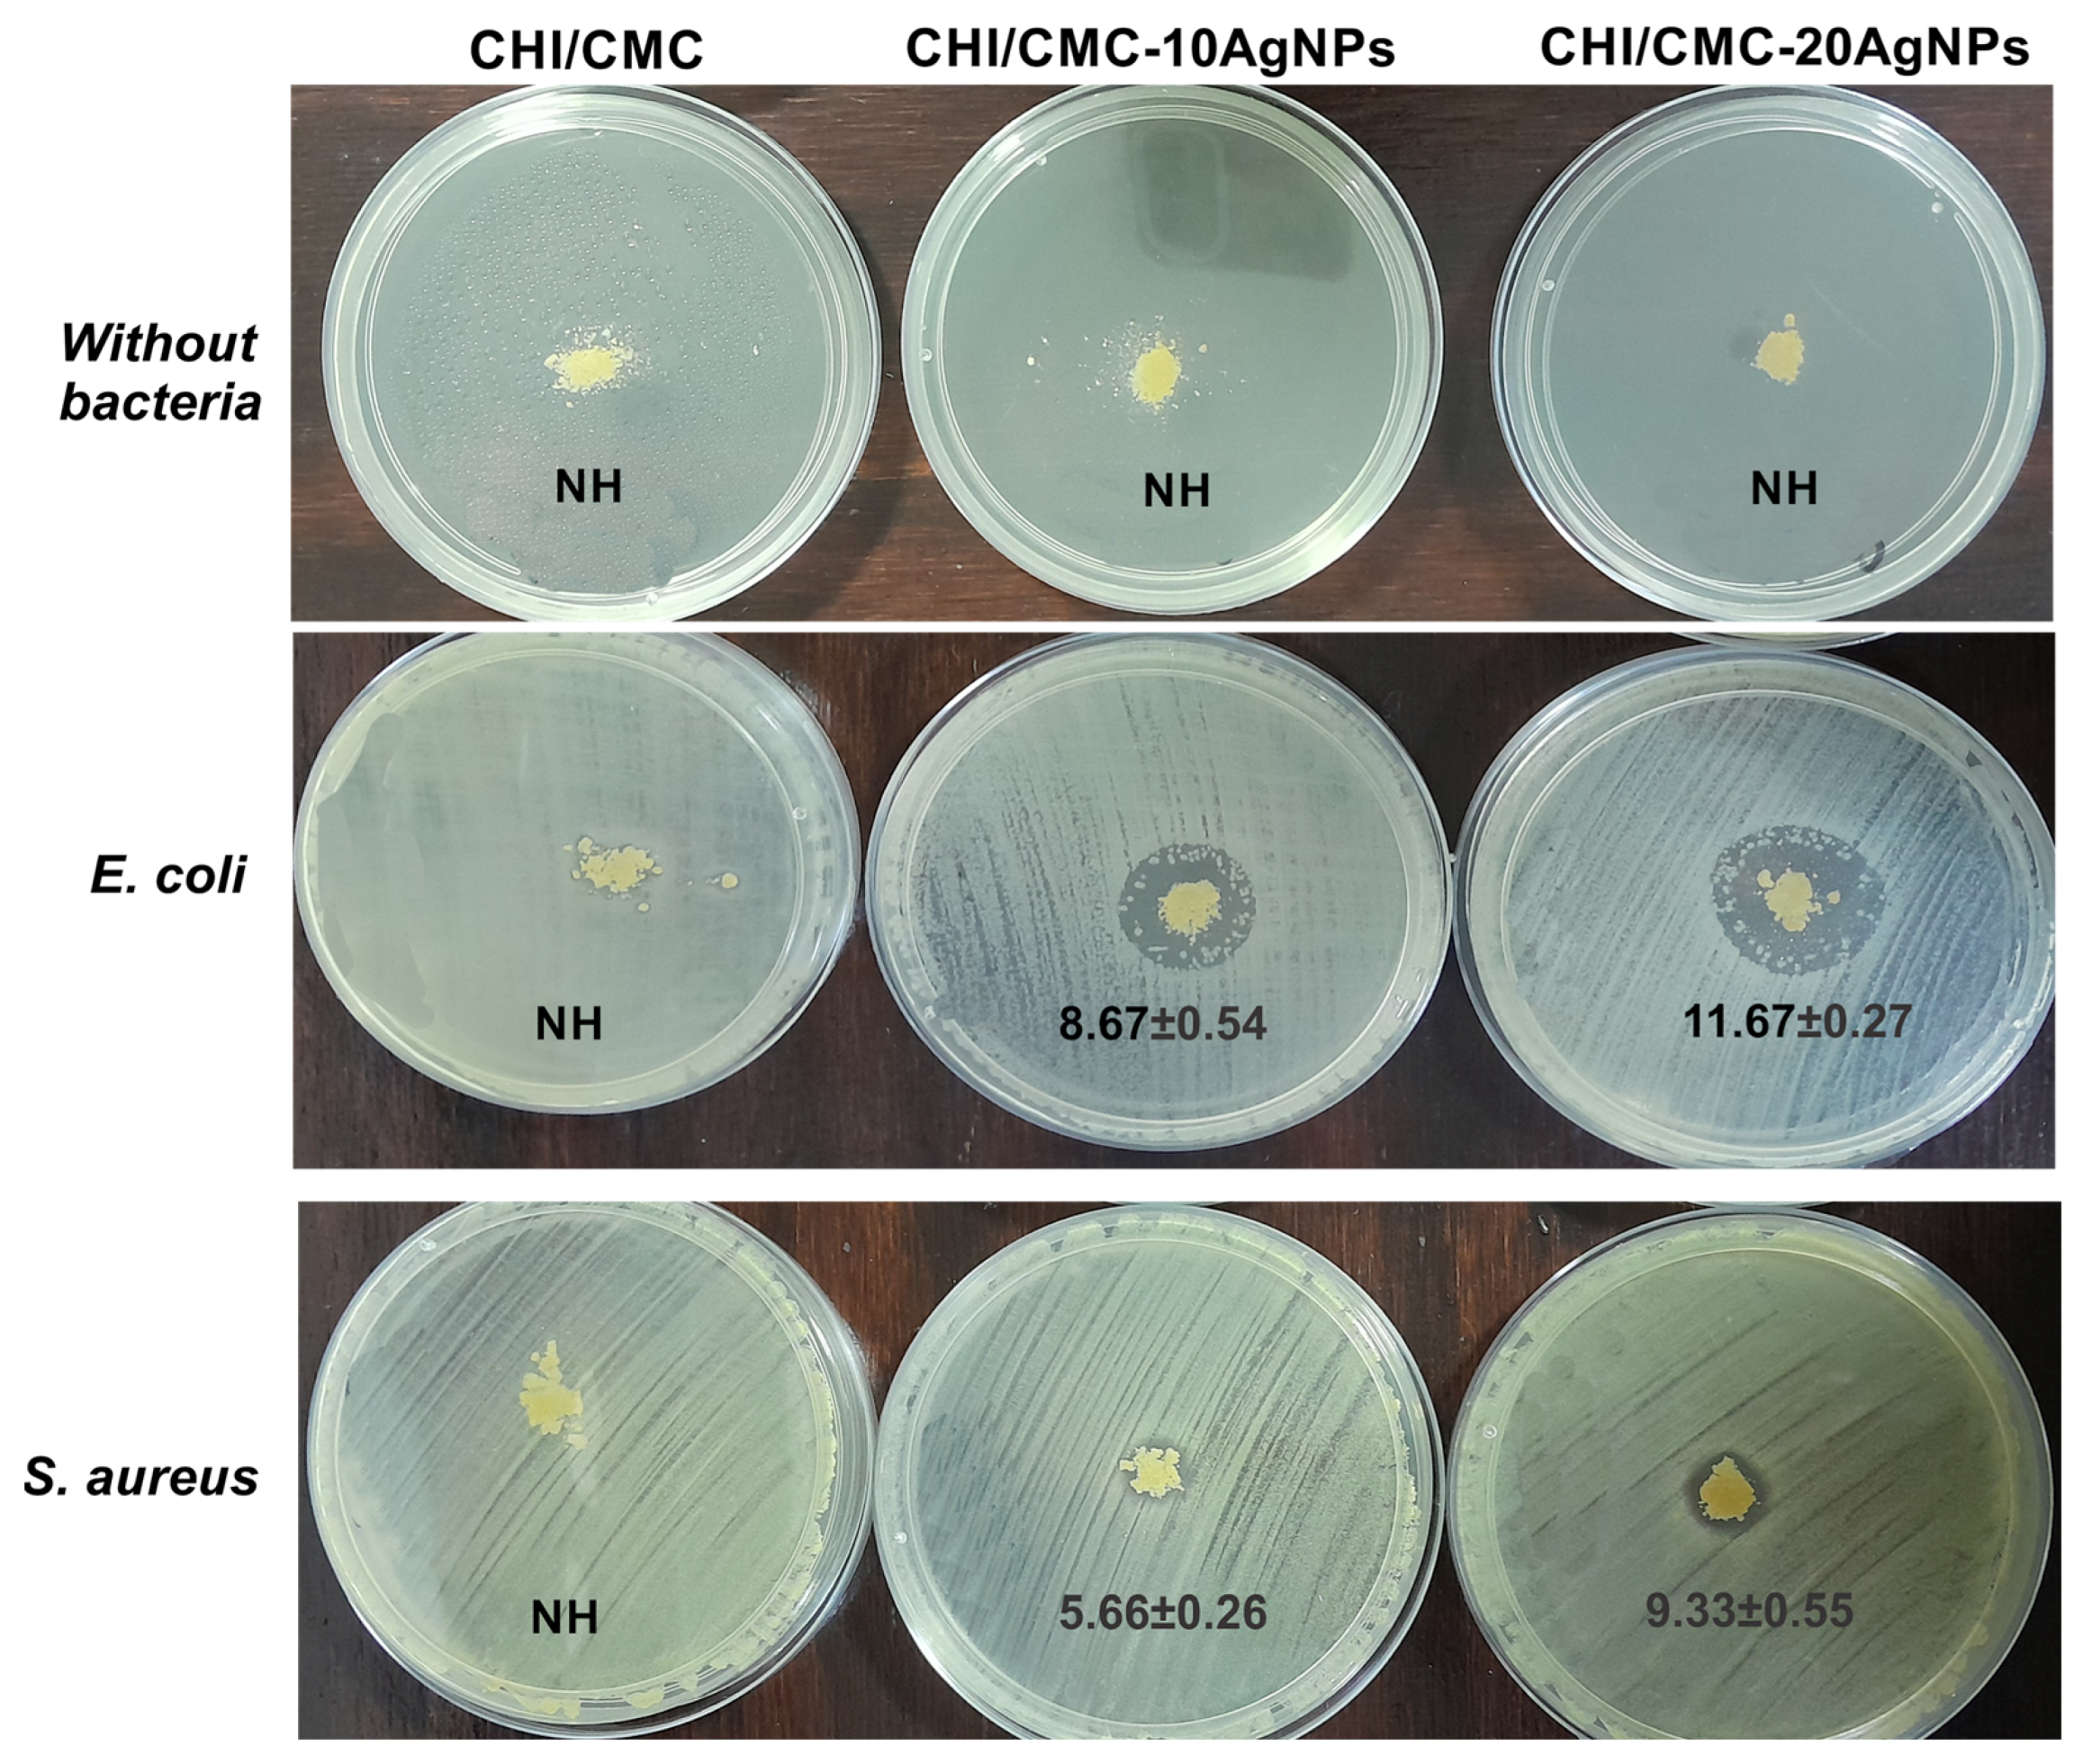

Polyelectrolyte Complex-Based Chitosan/Carboxymethylcellulose Powdered Microgels Loaded with Eco-Friendly Silver Nanoparticles as Innovative Biomaterials for Hemostasis Treatments
Abstract
1. Introduction
2. Materials and Methods
2.1. Polymers and Reagents
2.2. Green Synthesis of Silver Nanoparticles
2.3. Physicochemical Characterization of AgNPs-CMC
2.3.1. Transmission Electron Microscope (TEM)
2.3.2. Dynamic Light Scattering (DLS)
2.3.3. Nanoparticle Tracking Analysis (NTA)
2.3.4. FTIR Spectroscopy
2.3.5. UV-Visible Absorption Spectra
2.4. Microgel Formulation by Spray Drying
2.5. Obtaining Composite Microgels: Encapsulation of AgNPs-CMC in CHI/CMC
2.6. Characterization of CHI/CMC and CHI/CMC-AgNPs Microgels
2.6.1. Zeta-Potential
2.6.2. Scanning Electron Microscope (SEM)
2.6.3. ATR-FTIR Spectroscopy
2.6.4. Thermogravimetric Assay (TGA)
2.6.5. Swelling Test
2.6.6. Gel Fraction Test
2.6.7. Biodegradation Test
2.7. Antimicrobial Activity
2.8. Hemostatic Assays
2.8.1. Hemolysis Test
2.8.2. Blood Clotting Index
2.8.3. Coagulation Time
2.9. Statistical Analysis and Data Processing
3. Results and Discussion
3.1. Silver Nanoparticles: Green Synthesis and Characterization
3.2. CHI/CMC Microgel Formulation: Synthesis and Reaction Yield
3.3. Morphological, Physicochemical, and Thermal Characterization of CHI/CMC and CHI/CMC-AgNPs Microgels
3.4. Swelling, Gel Fraction, and Biodegradation of Microgels
3.5. Antimicrobial Assays
3.6. Hemostatic Capacity of Microgels
4. Conclusions
Supplementary Materials
Author Contributions
Funding
Institutional Review Board Statement
Data Availability Statement
DURC Statement
Acknowledgments
Conflicts of Interest
Abbreviations
| CHI | Chitosan |
| CMC | Carboxymethyl cellulose |
| PECs | Polyelectrolyte complexes |
| AgNPs | Silver nanoparticles |
| Mv | Average molecular weight |
| DS | Degree of substitution |
| DD% | Degree of deacetylation |
| AgNPs-CMC | Silver nanoparticles obtained with carboxymethyl cellulose |
| SPR | Surface plasmon resonance |
| GF | Gel fraction |
| PBS | Phosphate-buffered saline |
| BCI | Blood clotting index |
References
- Dorgalaleh, A.; Daneshi, M.; Rashidpanah, J.; Roshani Yasaghi, E. An Overview of Hemostasis. In Congenital Bleeding Disorders: Diagnosis and Management; Dorgalaleh, A., Ed.; Springer International Publishing: Cham, Switzerland, 2018; ISBN 978-3-319-76723-9. [Google Scholar]
- Kalkwarf, K.J.; Drake, S.A.; Yang, Y.; Thetford, C.; Myers, L.; Brock, M.; Wolf, D.A.; Persse, D.; Wade, C.E.; Holcomb, J.B. Bleeding to Death in a Big City: An Analysis of All Trauma Deaths from Hemorrhage in a Metropolitan Area during 1 Year. J. Trauma Acute Care Surg. 2020, 89, 716–722. [Google Scholar] [CrossRef]
- Queirós, E.C.; Pinheiro, S.P.; Pereira, J.E.; Prada, J.; Pires, I.; Dourado, F.; Parpot, P.; Gama, M. Hemostatic Dressings Made of Oxidized Bacterial Nanocellulose Membranes. Polysaccharides 2021, 2, 80–99. [Google Scholar] [CrossRef]
- Ren, Z.; Wang, Y.; Wu, H.; Cong, H.; Yu, B.; Shen, Y. Preparation and Application of Hemostatic Microspheres Containing Biological Macromolecules and Others. Int. J. Biol. Macromol. 2024, 257, 128299. [Google Scholar] [CrossRef] [PubMed]
- Huang, H.; Chen, H.; Wang, X.; Qiu, F.; Liu, H.; Lu, J.; Tong, L.; Yang, Y.; Wang, X.; Wu, H. Degradable and Bioadhesive Alginate-Based Composites: An Effective Hemostatic Agent. ACS Biomater. Sci. Eng. 2019, 5, 5498–5505. [Google Scholar] [CrossRef] [PubMed]
- Pourshahrestani, S.; Zeimaran, E.; Kadri, N.A.; Mutlu, N.; Boccaccini, A.R. Polymeric Hydrogel Systems as Emerging Biomaterial Platforms to Enable Hemostasis and Wound Healing. Adv. Healthc. Mater. 2020, 9, 2000905. [Google Scholar] [CrossRef]
- Guo, Y.; Xie, X.; Li, J.; Yao, S. Recent Advances in Natural Polysaccharide-Based Hemostatic Sponges: A Review. Polysaccharides 2025, 6, 25. [Google Scholar] [CrossRef]
- Shen, Z.-S.; Cui, X.; Hou, R.-X.; Li, Q.; Deng, H.-X.; Fu, J. Tough Biodegradable Chitosan–Gelatin Hydrogels via in Situ Precipitation for Potential Cartilage Tissue Engineering. RSC Adv. 2015, 5, 55640–55647. [Google Scholar] [CrossRef]
- Peniche, C.; Argüelles-Monal, W.; Goycoolea, F.M. Chapter 25—Chitin and Chitosan: Major Sources, Properties and Applications. In Monomers, Polymers and Composites from Renewable Resources; Belgacem, M.N., Gandini, A., Eds.; Elsevier: Amsterdam, The Netherlands, 2008; pp. 517–542. ISBN 978-0-08-045316-3. [Google Scholar]
- Yang, J.; Wang, Y.; Wei, A.; Peng, K.; Huang, R.; Wang, Z.; Ma, X.; Tian, Q.; Chen, Y. Polyelectrolyte Composite Hydrogels Based on a Derivative of Functional Dietary Fiber for Long-Term Gastric Retention and Drug Delivery. Compos. Part B Eng. 2024, 272, 111194. [Google Scholar] [CrossRef]
- Muzzio, N.E.; Pasquale, M.A.; Diamanti, E.; Gregurec, D.; Moro, M.M.; Azzaroni, O.; Moya, S.E. Enhanced Antiadhesive Properties of Chitosan/Hyaluronic Acid Polyelectrolyte Multilayers Driven by Thermal Annealing: Low Adherence for Mammalian Cells and Selective Decrease in Adhesion for Gram-Positive Bacteria. Mater. Sci. Eng. C 2017, 80, 677–687. [Google Scholar] [CrossRef] [PubMed]
- Yang, D.; Gong, L.; Li, Q.; Fan, B.; Ma, C.; He, Y.C. Preparation of a Biobased Polyelectrolyte Complex from Chitosan and Sodium Carboxymethyl Cellulose and Its Antibacterial Characteristics. Int. J. Biol. Macromol. 2023, 227, 524–534. [Google Scholar] [CrossRef]
- Tsai, R.Y.; Chen, P.W.; Kuo, T.Y.; Lin, C.M.; Wang, D.M.; Hsien, T.Y.; Hsieh, H.J. Chitosan/Pectin/Gum Arabic Polyelectrolyte Complex: Process-Dependent Appearance, Microstructure Analysis and Its Application. Carbohydr. Polym. 2014, 101, 752–759. [Google Scholar] [CrossRef]
- Fang, Y.; Guo, W.; Ni, P.; Liu, H. Recent Research Advances in Polysaccharide-Based Hemostatic Materials: A Review. Int. J. Biol. Macromol. 2024, 271, 132559. [Google Scholar] [CrossRef]
- Li, J.; Wu, X.; Wu, Y.; Tang, Z.; Sun, X.; Pan, M.; Chen, Y.; Li, J.; Xiao, R.; Wang, Z.; et al. Porous Chitosan Microspheres for Application as Quick In Vitro and In Vivo Hemostat. Mater. Sci. Eng. C 2017, 77, 411–419. [Google Scholar] [CrossRef]
- Jin, J.; Ji, Z.; Xu, M.; Liu, C.; Ye, X.; Zhang, W.; Li, S.; Wang, D.; Zhang, W.; Chen, J.; et al. Microspheres of Carboxymethyl Chitosan, Sodium Alginate, and Collagen as a Hemostatic Agent In Vivo. ACS Biomater. Sci. Eng. 2018, 4, 2541–2551. [Google Scholar] [CrossRef]
- Bi, Y.-G.; Lin, Z.-T.; Deng, S.-T. Fabrication and Characterization of Hydroxyapatite/Sodium Alginate/Chitosan Composite Microspheres for Drug Delivery and Bone Tissue Engineering. Mater. Sci. Eng. C 2019, 100, 576–583. [Google Scholar] [CrossRef]
- Antezana, P.E.; Municoy, S.; Pérez, C.J.; Desimone, M.F. Collagen Hydrogels Loaded with Silver Nanoparticles and Cannabis Sativa Oil. Antibiotics 2021, 10, 1420. [Google Scholar] [CrossRef]
- Liu, R.; Dai, L.; Si, C.; Zeng, Z. Antibacterial and Hemostatic Hydrogel via Nanocomposite from Cellulose Nanofibers. Carbohydr. Polym. 2018, 195, 63–70. [Google Scholar] [CrossRef] [PubMed]
- Arshad, F.; Naikoo, G.A.; Hassan, I.U.; Chava, S.R.; El-Tanani, M.; Aljabali, A.A.; Tambuwala, M.M. Bioinspired and Green Synthesis of Silver Nanoparticles for Medical Applications: A Green Perspective. Appl. Biochem. Biotechnol. 2024, 196, 3636–3669. [Google Scholar] [CrossRef] [PubMed]
- Mardani, M.; Siahtiri, S.; Besati, M.; Baghani, M.; Baniassadi, M.; Nejad, A.M. Microencapsulation of Natural Products Using Spray Drying; an Overview. J. Microencapsul. 2024, 41, 649–678. [Google Scholar] [CrossRef] [PubMed]
- Mohammed, N.K.; Tan, C.P.; Manap, Y.A.; Muhialdin, B.J.; Hussin, A.S.M. Spray Drying for the Encapsulation of Oils—A Review. Molecules 2020, 25, 3873. [Google Scholar] [CrossRef]
- Liang, Y.; Xu, C.; Liu, F.; Du, S.; Li, G.; Wang, X. Eliminating Heat Injury of Zeolite in Hemostasis via Thermal Conductivity of Graphene Sponge. ACS Appl. Mater. Interfaces 2019, 11, 23848–23857. [Google Scholar] [CrossRef]
- Wang, L.; You, X.; Dai, C.; Tong, T.; Wu, J. Hemostatic Nanotechnologies for External and Internal Hemorrhage Management. Biomater. Sci. 2020, 8, 4396–4412. [Google Scholar] [CrossRef]
- Ferrante, M.; Gallo, M.B.; Gende, L.B.; Consolo, V.F.; Álvarez, V.A.; González, J.S. Synthesis and Characterization of Gelatin/Chondroitin Sulfate Microgels with NaCl: Preliminary Research toward Wound Healing Applications. Int. J. Biol. Macromol. 2025, 290, 138953. [Google Scholar] [CrossRef]
- Kim, G.H.; Im, J.N.; Kim, T.H.; Lee, G.D.; Youk, J.H.; Doh, S.J. Preparation and Characterization of Calcium Carboxymethyl Cellulose/Chitosan Blend Nonwovens for Hemostatic Agents. Text. Res. J. 2018, 88, 1902–1911. [Google Scholar] [CrossRef]
- Qian, J.; Wang, X.; Chen, Y.; Mo, C.; Liang, C.; Guo, H. The Correlation of Molecule Weight of Chitosan Oligomers with the Corresponding Viscosity and Antibacterial Activity. Carbohydr. Res. 2023, 530, 108860. [Google Scholar] [CrossRef] [PubMed]
- Czechowska-Biskup, R.; Wach, R.A.; Rosiak, J.M.; Ulański, P. Procedure for Determination of the Molecular Weight of Chitosan by Viscometry. Prog. Chem. Appl. Chitin Its Deriv. 2018, 23, 45–54. [Google Scholar] [CrossRef]
- Roberts, G.A.F.; Domszy, J.G. Determination of the Viscometric Constants for Chitosan. Int. J. Biol. Macromol. 1982, 4, 374–377. [Google Scholar] [CrossRef]
- Gómez-Díaz, D.; Navaza, J.M. Rheology of Aqueous Solutions of Food Additives: Effect of Concentration, Temperature and Blending. J. Food Eng. 2003, 56, 387–392. [Google Scholar] [CrossRef]
- Eremeeva, T.E.; Bykova, T.O. SEC of Mono-Carboxymethyl Cellulose (CMC) in a Wide Range of pH; Mark–Houwink Constants. Carbohydr. Polym. 1998, 36, 319–326. [Google Scholar] [CrossRef]
- Singh, R.K.; Khatri, O.P. A Scanning Electron Microscope Based New Method for Determining Degree of Substitution of Sodium Carboxymethyl Cellulose. J. Microsc. 2012, 246, 43–52. [Google Scholar] [CrossRef]
- Liu, D.; Wei, Y.; Yao, P.; Jiang, L. Determination of the Degree of Acetylation of Chitosan by UV Spectrophotometry Using Dual Standards. Carbohydr. Res. 2006, 341, 782–785. [Google Scholar] [CrossRef] [PubMed]
- Sánchez-Machado, D.I.; López-Cervantes, J.; Escárcega-Galaz, A.A.; Campas-Baypoli, O.N.; Martínez-Ibarra, D.M.; Rascón-León, S. Measurement of the Degree of Deacetylation in Chitosan Films by FTIR, 1H NMR and UV Spectrophotometry. MethodsX 2024, 12, 102583. [Google Scholar] [CrossRef]
- Duarte, M.L.; Ferreira, M.C.; Marvão, M.R.; Rocha, J. An Optimised Method to Determine the Degree of Acetylation of Chitin and Chitosan by FTIR Spectroscopy. Int. J. Biol. Macromol. 2002, 31, 1–8. [Google Scholar] [CrossRef]
- Dutta, J. Priyanka A Facile Approach for the Determination of Degree of Deacetylation of Chitosan Using Acid-Base Titration. Heliyon 2022, 8, e09924. [Google Scholar] [CrossRef]
- Kasaai, M.R. A Review of Several Reported Procedures to Determine the Degree of N-Acetylation for Chitin and Chitosan Using Infrared Spectroscopy. Carbohydr. Polym. 2008, 71, 497–508. [Google Scholar] [CrossRef]
- Domard, A.; Rinaudo, M. Preparation and Characterization of Fully Deacetylated Chitosan. Int. J. Biol. Macromol. 1983, 5, 49–52. [Google Scholar] [CrossRef]
- Capanema, N.S.V.; Mansur, A.A.P.; Carvalho, S.M.; Mansur, L.L.; Ramos, C.P.; Lage, A.P.; Mansur, H.S. Physicochemical Properties and Antimicrobial Activity of Biocompatible Carboxymethylcellulose-Silver Nanoparticle Hybrids for Wound Dressing and Epidermal Repair. J. Appl. Polym. Sci. 2018, 135, 45812. [Google Scholar] [CrossRef]
- Filipe, V.; Hawe, A.; Jiskoot, W. Critical Evaluation of Nanoparticle Tracking Analysis (NTA) by NanoSight for the Measurement of Nanoparticles and Protein Aggregates. Pharm. Res. 2010, 27, 796–810. [Google Scholar] [CrossRef]
- Proksch, E. pH in Nature, Humans and Skin. J. Dermatol. 2018, 45, 1044–1052. [Google Scholar] [CrossRef]
- Ferrante, M.; Alvarez, V.A.; Gende, L.B.; Guerrieri, D.; Chuluyan, E.; Gonzalez, J.S. Polyelectrolyte Complexes Hydrogels Based on Chitosan/Pectin/NaCl for Potentially Wound Dressing: Development, Characterization, and Evaluation. Colloid Polym. Sci. 2024, 302, 1231–1245. [Google Scholar] [CrossRef]
- Archana, D.; Dutta, J.; Dutta, P.K. Evaluation of Chitosan Nano Dressing for Wound Healing: Characterization, in Vitro and in Vivo Studies. Int. J. Biol. Macromol. 2013, 57, 193–203. [Google Scholar] [CrossRef]
- Behrens, A.M.; Sikorski, M.J.; Li, T.; Wu, Z.J.; Griffith, B.P.; Kofinas, P. Blood-Aggregating Hydrogel Particles for Use as a Hemostatic Agent. Acta Biomater. 2014, 10, 701–708. [Google Scholar] [CrossRef] [PubMed]
- Nasrollahzadeh, M.; Sajjadi, M.; Sajadi, S.M.; Issaabadi, Z. Chapter 5—Green Nanotechnology. In Interface Science and Technology; Nasrollahzadeh, M., Sajadi, S.M., Sajjadi, M., Issaabadi, Z., Atarod, M., Eds.; An Introduction to Green Nanotechnology; Elsevier: Amsterdam, The Netherlands, 2019; Volume 28, pp. 145–198. [Google Scholar]
- Ahmad, S.; Munir, S.; Zeb, N.; Ullah, A.; Khan, B.; Ali, J.; Bilal, M.; Omer, M.; Alamzeb, M.; Salman, S.M.; et al. Green Nanotechnology: A Review on Green Synthesis of Silver Nanoparticles—An Ecofriendly Approach. Int. J. Nanomed. 2019, 14, 5087–5107. [Google Scholar] [CrossRef]
- Thakore, S. Role of Biopolymers in Green Nanotechnology; IntechOpen: London, UK, 2012. [Google Scholar]
- Abdel-Halim, E.S.; Alanazi, H.H.; Al-Deyab, S.S. Utilization of Hydroxypropyl Carboxymethyl Cellulose in Synthesis of Silver Nanoparticles. Int. J. Biol. Macromol. 2015, 75, 467–473. [Google Scholar] [CrossRef]
- Dara, P.K.; Mahadevan, R.; Digita, P.A.; Visnuvinayagam, S.; Kumar, L.R.G.; Mathew, S.; Ravishankar, C.N.; Anandan, R. Synthesis and Biochemical Characterization of Silver Nanoparticles Grafted Chitosan (Chi-Ag-NPs): In Vitro Studies on Antioxidant and Antibacterial Applications. SN Appl. Sci. 2020, 2, 665. [Google Scholar] [CrossRef]
- Wang, R.; Shou, D.; Lv, O.; Kong, Y.; Deng, L.; Shen, J. pH-Controlled Drug Delivery with Hybrid Aerogel of Chitosan, Carboxymethyl Cellulose and Graphene Oxide as the Carrier. Int. J. Biol. Macromol. 2017, 103, 248–253. [Google Scholar] [CrossRef]
- Danaei, M.; Dehghankhold, M.; Ataei, S.; Hasanzadeh Davarani, F.; Javanmard, R.; Dokhani, A.; Khorasani, S.; Mozafari, M.R. Impact of Particle Size and Polydispersity Index on the Clinical Applications of Lipidic Nanocarrier Systems. Pharmaceutics 2018, 10, 57. [Google Scholar] [CrossRef] [PubMed]
- Hebeish, A.A.; El-Rafie, M.H.; Abdel-Mohdy, F.A.; Abdel-Halim, E.S.; Emam, H.E. Carboxymethyl Cellulose for Green Synthesis and Stabilization of Silver Nanoparticles. Carbohydr. Polym. 2010, 82, 933–941. [Google Scholar] [CrossRef]
- Cerchiara, T.; Abruzzo, A.; Parolin, C.; Vitali, B.; Bigucci, F.; Gallucci, M.C.; Nicoletta, F.P.; Luppi, B. Microparticles Based on Chitosan/Carboxymethylcellulose Polyelectrolyte Complexes for Colon Delivery of Vancomycin. Carbohydr. Polym. 2016, 143, 124–130. [Google Scholar] [CrossRef] [PubMed]
- Halahlah, A.; Piironen, V.; Mikkonen, K.S.; Ho, T.M. Polysaccharides as Wall Materials in Spray-Dried Microencapsulation of Bioactive Compounds: Physicochemical Properties and Characterization. Crit. Rev. Food Sci. Nutr. 2023, 63, 6983–7015. [Google Scholar] [CrossRef] [PubMed]
- Tokárová, V.; Kašpar, O.; Knejzlík, Z.; Ulbrich, P.; Štěpánek, F. Development of Spray-Dried Chitosan Microcarriers for Nanoparticle Delivery. Powder Technol. 2013, 235, 797–805. [Google Scholar] [CrossRef]
- Altam, A.A.; Zhu, L.; Huang, W.; Huang, H.; Yang, S. Polyelectrolyte Complex Beads of Carboxymethylcellulose and Chitosan: The Controlled Formation and Improved Properties. Carbohydr. Polym. Technol. Appl. 2021, 2, 100100. [Google Scholar] [CrossRef]
- Tontul, I.; Topuz, A. Spray-Drying of Fruit and Vegetable Juices: Effect of Drying Conditions on the Product Yield and Physical Properties. Trends Food Sci. Technol. 2017, 63, 91–102. [Google Scholar] [CrossRef]
- Zhu, X.; Bao, L.; Wei, Y.; Ma, J.; Kong, Y. Removal of Toxic Indigo Blue with Integrated Biomaterials of Sodium Carboxymethyl Cellulose and Chitosan. Int. J. Biol. Macromol. 2016, 91, 409–415. [Google Scholar] [CrossRef] [PubMed]
- Elliott, J.E.; Macdonald, M.; Nie, J.; Bowman, C.N. Structure and Swelling of Poly(Acrylic Acid) Hydrogels: Effect of pH, Ionic Strength, and Dilution on the Crosslinked Polymer Structure. Polymer 2004, 45, 1503–1510. [Google Scholar] [CrossRef]
- De Yao, K.; Liu, J.; Cheng, G.X.; Lu, X.D.; Tu, H.L.; Da Silva, J.A.L. Swelling Behavior of Pectin/Chitosan Complex Films. J. Appl. Polym. Sci. 1996, 60, 279–283. [Google Scholar] [CrossRef]
- De Piano, R.; Caccavo, D.; Barba, A.A.; Lamberti, G. Swelling Behavior of Anionic Hydrogels: Experiments and Modeling. Gels 2024, 10, 813. [Google Scholar] [CrossRef]
- Wang, R.; Cheng, C.; Wang, H.; Wang, D. Swollen Hydrogel Nanotechnology: Advanced Applications of the Rudimentary Swelling Properties of Hydrogels. ChemPhysMater 2024, 3, 357–375. [Google Scholar] [CrossRef]
- Neuffer, M.C.; McDivitt, J.; Rose, D.; King, K.; Cloonan, C.C.; Vayer, J.S. Hemostatic Dressings for the First Responder: A Review. Mil. Med. 2004, 169, 716–720. [Google Scholar] [CrossRef][Green Version]
- Sun, X.; Fang, Y.; Tang, Z.; Wang, Z.; Liu, X.; Liu, H. Mesoporous Silica Nanoparticles Carried on Chitosan Microspheres for Traumatic Bleeding Control. Int. J. Biol. Macromol. 2019, 127, 311–319. [Google Scholar] [CrossRef]
- Pankratov, T.A.; Gannesen, A.V.; Nikolaev, Y.A. Regulation of Lysozyme Activity by Human Hormones. Iran Biomed. J. 2023, 27, 58–65. [Google Scholar] [CrossRef] [PubMed]
- Sahiner, M.; Yilmaz, A.S.; Ayyala, R.S.; Sahiner, N. Carboxymethyl Chitosan Microgels for Sustained Delivery of Vancomycin and Long-Lasting Antibacterial Effects. Gels 2023, 9, 708. [Google Scholar] [CrossRef]
- Correia, C.R.; Moreira-Teixeira, L.S.; Moroni, L.; Reis, R.L.; van Blitterswijk, C.A.; Karperien, M.; Mano, J.F. Chitosan Scaffolds Containing Hyaluronic Acid for Cartilage Tissue Engineering. Tissue Eng. Part C Methods 2011, 17, 717–730. [Google Scholar] [CrossRef]
- Chen, C.; Liu, M.; Lii, S.; Gao, C.; Chen, J. In Vitro Degradation and Drug-Release Properties of Water-Soluble Chitosan Cross-Linked Oxidized Sodium Alginate Core–Shell Microgels. J. Biomater. Sci. Polym. Ed. 2012, 23, 2007–2024. [Google Scholar] [CrossRef]
- Franci, G.; Falanga, A.; Galdiero, S.; Palomba, L.; Rai, M.; Morelli, G.; Galdiero, M. Silver Nanoparticles as Potential Antibacterial Agents. Molecules 2015, 20, 8856–8874. [Google Scholar] [CrossRef]
- Omoteso, O.A.; Fadaka, A.O.; Walker, R.B.; Khamanga, S.M. Innovative Strategies for Combating Multidrug-Resistant Tuberculosis: Advances in Drug Delivery Systems and Treatment. Microorganisms 2025, 13, 722. [Google Scholar] [CrossRef]
- Peiris, M.M.K.; Fernando, S.S.N.; Jayaweera, P.M.; Arachchi, N.D.H.; Guansekara, T.D.C.P. Comparison of Antimicrobial Properties of Silver Nanoparticles Synthesized from Selected Bacteria. Indian J. Microbiol. 2018, 58, 301–311. [Google Scholar] [CrossRef]
- Maher, C.; Hassan, K.A. The Gram-Negative Permeability Barrier: Tipping the Balance of the in and the Out. mBio 2023, 14, e0120523. [Google Scholar] [CrossRef]
- Khaldoun, K.; Khizar, S.; Saidi-Besbes, S.; Zine, N.; Errachid, A.; Elaissari, A. Synthesis of Silver Nanoparticles as an Antimicrobial Mediator. J. Umm Al-Qura Univ. Appl. Sci. 2025, 11, 274–293. [Google Scholar] [CrossRef]
- Laanoja, J.; Sihtmäe, M.; Vija, H.; Kurvet, I.; Otsus, M.; Šmits, K.; Kahru, A.; Kasemets, K. Particle-Driven Synergistic Antibacterial Effect of Silver–Chitosan Nanocomposites Against Escherichia coli, Pseudomonas aeruginosa, and Staphylococcus aureus. ACS Omega 2025, 10, 27904–27919. [Google Scholar] [CrossRef] [PubMed]

| CHI/CMC | CHI/CMC-10AgNPs | CHI/CMC-20AgNPs | |
|---|---|---|---|
| Degradation temperature (Tp, °C) | 241.26 ± 1.00 | 246.93 ± 1.50 * | 242.55 ± 1.10 |
| Weight loss at Tp (%) | 32.43 ± 0.60 | 35.28 ± 0.50 | 32.78 ± 1.00 |
| Residual Mass at 880 °C (%) | 15.64 ± 1.20 | 20.94 ± 1.20 * | 21.90 ± 1.30 * |
| Sample | Hemolysis (%) | Coagulation Time (%) | BCI (%) | |||
|---|---|---|---|---|---|---|
| 5 min | 10 min | 15 min | 30 min | |||
| Whole Blood | - | 100.00 ± 0.39 | 36.47 ± 0.60 | 5.17 ± 0.22 | 0.52 ± 0.02 | 0.38 ± 0.04 |
| CHI/CMC | 3.08 ± 0.46 | 82.49 ± 2.45 * | 10.50 ± 0.14 * | 4.70 ± 0.22 | 0.52 ± 0.11 | 0.33 ± 0.08 |
| CHI/CMC-10AgNPs | 5.11 ± 0.36 a | 80.84 ± 2.83 * | 15.20 ± 0.20 * | 3.61 ± 0.19 * | 0.55 ± 0.13 | 0.39 ± 0.03 |
| CHI/CMC-20AgNPs | 13.06 ±1.37 a,b | 81.35 ± 0.40 * | 14.32 ± 0.25 * | 5.75 ± 0.11 a,b | 1.05 ± 0.26 a,b,* | 0.78 ± 0.07 a,b,* |
Disclaimer/Publisher’s Note: The statements, opinions and data contained in all publications are solely those of the individual author(s) and contributor(s) and not of MDPI and/or the editor(s). MDPI and/or the editor(s) disclaim responsibility for any injury to people or property resulting from any ideas, methods, instructions or products referred to in the content. |
© 2025 by the authors. Licensee MDPI, Basel, Switzerland. This article is an open access article distributed under the terms and conditions of the Creative Commons Attribution (CC BY) license (https://creativecommons.org/licenses/by/4.0/).
Share and Cite
Gonzalez, A.; Ferrante, M.; Gende, L.; Alvarez, V.A.; Gonzalez, J.S. Polyelectrolyte Complex-Based Chitosan/Carboxymethylcellulose Powdered Microgels Loaded with Eco-Friendly Silver Nanoparticles as Innovative Biomaterials for Hemostasis Treatments. Polysaccharides 2025, 6, 84. https://doi.org/10.3390/polysaccharides6030084
Gonzalez A, Ferrante M, Gende L, Alvarez VA, Gonzalez JS. Polyelectrolyte Complex-Based Chitosan/Carboxymethylcellulose Powdered Microgels Loaded with Eco-Friendly Silver Nanoparticles as Innovative Biomaterials for Hemostasis Treatments. Polysaccharides. 2025; 6(3):84. https://doi.org/10.3390/polysaccharides6030084
Chicago/Turabian StyleGonzalez, Ariel, Micaela Ferrante, Liesel Gende, Vera A. Alvarez, and Jimena S. Gonzalez. 2025. "Polyelectrolyte Complex-Based Chitosan/Carboxymethylcellulose Powdered Microgels Loaded with Eco-Friendly Silver Nanoparticles as Innovative Biomaterials for Hemostasis Treatments" Polysaccharides 6, no. 3: 84. https://doi.org/10.3390/polysaccharides6030084
APA StyleGonzalez, A., Ferrante, M., Gende, L., Alvarez, V. A., & Gonzalez, J. S. (2025). Polyelectrolyte Complex-Based Chitosan/Carboxymethylcellulose Powdered Microgels Loaded with Eco-Friendly Silver Nanoparticles as Innovative Biomaterials for Hemostasis Treatments. Polysaccharides, 6(3), 84. https://doi.org/10.3390/polysaccharides6030084

